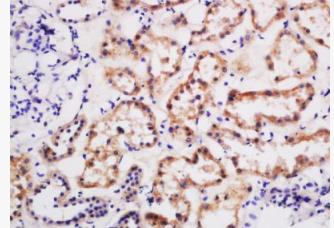
image.png

Rabbit Anti-BTR1 Polyclonal Antibody
DATASHEET
Host:Rabbit
Target Protein:BTR1
IR:Immunogen Range:751-850/891
Clonality:Polyclonal
Isotype:IgG
Entrez Gene:83959
Swiss Prot:Q8NBS3
Source:KLH conjugated synthetic peptide derived from human BTR1:751-850/891
Purification:affinity purified by Protein A
Storage:0.01M TBS(pH7.4) with 1% BSA, 0.03% Proclin300 and 50% Glycerol. Shipped at 4℃. Store at -20 °C for one year. Avoid repeated freeze/thaw cycles.
Background:BtR1 is a cadherin receptor from the tobacco hornworm Manduca sexta.
Size:50ul
Concentration:1mg/ml
Applications:ELISA(1:5000-10000)
IHC-P(1:100-500)
IHC-F(1:100-500)
ICC(1:100-500)
IF(1:100-500)
Cross Reactive Species:Human
Mouse
Rat
Chicken
Dog
Cow
Horse
Sheep
仅供科研使用。不能用于人和动物治疗等其它临床诊断用!
关键字: BTR1;BT R1;NaBC1;SLC4A11;sodium bicarbonate t;transporter;bicarbonate ;S4A11_HUMAN;
上海沪震实业有限公司是一家集研发、生产和销售于一体的生命科学实验室产品生物科技企业。主营产品:试剂盒,ELISA试剂盒,抗体,重组蛋白,血清,胎牛血清,细胞,原代细胞 细胞培养试剂,常用生化试剂。